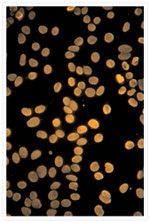
Mouse IgG (H+L) Cross-Adsorbed Secondary Antibody in Immunocytochemistry (ICC/IF)

Search
Invitrogen
Goat anti-Mouse IgG (H+L) Cross-Adsorbed Secondary Antibody, Alexa Fluor™ 546
{{$productOrderCtrl.translations['antibody.pdp.commerceCard.promotion.promotions']}}
{{$productOrderCtrl.translations['antibody.pdp.commerceCard.promotion.viewpromo']}}
{{$productOrderCtrl.translations['antibody.pdp.commerceCard.promotion.promocode']}}: {{promo.promoCode}} {{promo.promoTitle}} {{promo.promoDescription}}. {{$productOrderCtrl.translations['antibody.pdp.commerceCard.promotion.learnmore']}}
图: 1 / 44
Mouse IgG (H+L) Cross-Adsorbed Secondary Antibody (A-11003) in ICC/IF

Please note: We are reviewing Western blot images included in the antibody testing data in our catalog, including those provided by third parties. Unless expressly labeled or annotated as “raw-unedited”, Western blot images included in the antibody testing data in our catalog may have been edited, optimized or otherwise adjusted for presentation.
产品信息
A-11003
免疫细胞化学 (ICC/IF)
流式细胞分析 (Flow)
种属反应
宿主/亚型
分类
类型
抗原
偶联物
激发/发射光谱
形式
浓度
规格
纯化类型
保存液
内含物
保存条件
运输条件
RRID
靶标
交叉吸附
抗体形式
产品详细信息
To minimize cross-reactivity, these goat anti-mouse IgG (H+L) whole secondary antibodies have been affinity purified and cross-adsorbed against human IgG and human serum prior to conjugation. Cross-adsorption or pre-adsorption is a purification step to increase specificity of the antibody resulting in higher sensitivity and less background staining. The secondary antibody solution is passed through a column matrix containing immobilized serum proteins from potentially cross-reactive species. Only the nonspecific-binding secondary antibodies are captured in the column, and the highly specific secondaries flow through. The benefits of this extra step are apparent in multiplexing/multicolor-staining experiments (e.g., flow cytometry) where there is potential cross-reactivity with other primary antibodies or in tissue/cell fluorescent staining experiments where there are may be the presence of endogenous immunoglobulins.
Alexa Fluor dyes are among the most trusted fluorescent dyes available today. Invitrogen™ Alexa Fluor 546 dye is a bright, orange-fluorescent dye with excitation ideally suited to the 546 nm laser line. For stable signal generation in imaging and flow cytometry, Alexa Fluor 546 dye is pH-insensitive over a wide molar range. Probes with high fluorescence quantum yield and high photostability allow detection of low-abundance biological structures with great sensitivity. Alexa Fluor 546 dye molecules can be attached to proteins at high molar ratios without significant self-quenching, enabling brighter conjugates and more sensitive detection. The degree of labeling for each conjugate is typically 2-8 fluorophore molecules per IgG molecule; the exact degree of labeling is indicated on the certificate of analysis for each product lot.
Using conjugate solutions: Centrifuge the protein conjugate solution briefly in a microcentrifuge before use; add only the supernatant to the experiment. This step will help eliminate any protein aggregates that may have formed during storage, thereby reducing nonspecific background staining. Because staining protocols vary with application, the appropriate dilution of antibody should be determined empirically. For the fluorophore-labeled antibodies a final concentration of 1-10 µg/mL should be satisfactory for most immunohistochemistry and flow cytometry applications.
Product will be shipped at Room Temperature.
靶标信息
Anti-Mouse secondary antibodies are affinity-purified antibodies with well-characterized specificity for mouse immunoglobulins and are useful in the detection, sorting or purification of its specified target. Secondary antibodies offer increased versatility enabling users to use many detection systems (e.g. HRP, AP, fluorescence). They can also provide greater sensitivity through signal amplification as multiple secondary antibodies can bind to a single primary antibody. Most commonly, secondary antibodies are generated by immunizing the host animal with a pooled population of immunoglobulins from the target species and can be further purified and modified (i.e. immunoaffinity chromatography, antibody fragmentation, label conjugation, etc.) to generate highly specific reagents.
仅用于科研。不用于诊断过程。未经明确授权不得转售。




